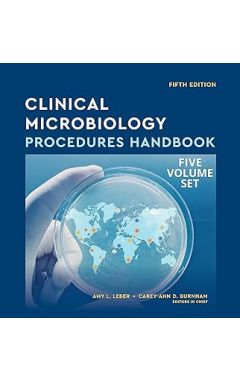
Clinical Microbiology Procedures Handbook, Multi-Volume 5th edition

אנו משתמשים ב-Cookies כדי לשפר את החוויה שלך. כדי לקיים ההנחיה החדשה של e-Privacy, עלינו לבקש את הסכמתך להגדיר את ה-Cookies. קבלת מידע נוסף.
The Brain: The Story of You
מחיר מבצע
40.00 ₪
מחיר רגיל
80.00 ₪
ISBN13
9781782116615
Author
David Eagleman
הוצאה לאור
Canongate Books
זמן אספקה
במלאי, (זמן אספקה 5 ימי עסקים)
עמודים / Pages
224
פורמט
Paperback
תאריך יציאה לאור
7 באפר׳ 2016
'This is the story of how your life shapes your brain, and how your brain shapes your life.' Join renowned neuroscientist David Eagleman on a whistle-stop tour of the inner cosmos. It's a journey that will take you into the world of extreme sports, criminal justice, genocide, brain surgery, robotics and the search for immortality. On the way, amidst the infinitely dense tangle of brain cells and their trillions of connections, something emerges that you might not have expected to see: you.
-
Conundrums and Predicaments in Psychotherapy and Psychoanalysis: The Clinical Moments Projectמחיר מבצע 199.00 ₪ מחיר רגיל 276.00 ₪ -
The Holy Grail of Investing: The World's Greatest Investors Reveal Their Ultimate Strategies foמחיר מבצע 62.00 ₪ מחיר רגיל 117.00 ₪ -
The Book of Overthinking: How to Stop the Cycle of Worryמחיר מבצע 47.00 ₪ מחיר רגיל 69.00 ₪ -
Unwinding Anxiety: Train Your Brain to Heal Your Mindמחיר מבצע 89.00 ₪ מחיר רגיל 95.00 ₪ -
What Happened to You?: Conversations on Trauma, Resilience, and Hמחיר מבצע 64.00 ₪ מחיר רגיל 111.00 ₪ -
A Human History of Emotion: How the Way We Feel Built the World We Knowמחיר מבצע 99.00 ₪ מחיר רגיל 138.00 ₪
| עמודים / Pages | 224 |
|---|---|
| פורמט | Paperback |
| הוצאה לאור | Canongate Books |
| תאריך יציאה לאור | 7 באפר׳ 2016 |
| Author | David Eagleman |

Login and Registration Form